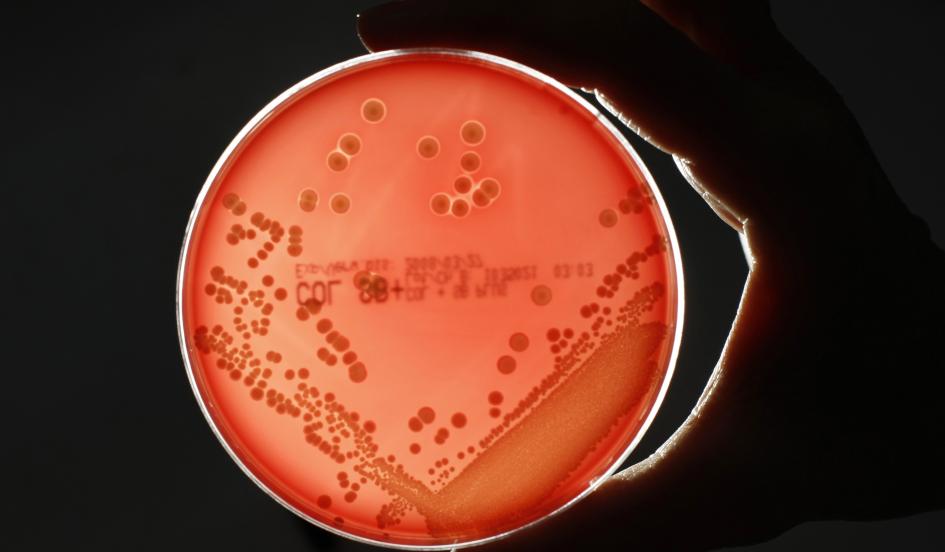
Revolutionary new antibiotic alternative could save the world from superbug "apocalypse" — bit.ly/1y9FYT1

Salih Cem Bağcı
@salihcembagci
Dt. PhD @İÜDHF Endodontics
ID: 65862705
http://instagram.com/dentney 15-08-2009 08:49:47
2,2K Tweet
228 Takipçi
515 Takip Edilen





TradingView dm ile ulaşarak Black Friday indirimi adına bir takipçime 12 AYLIK 🎁 Premium paket hediye etmek istediğini iletti. Bunu bir çekilişle halledelim. Katılmak için bu tweeti RT etmek yeterli. BeyazYakaGiyer ve TradingView Türkiye 🇹🇷 hesaplarını takip etme şartı bulunmuyor.













Zenginin uçağı düşer; iyi oldu derler Fakir inşaattan düşer; banane derler Asker şehit olur; ne mutlu ona derler Madenci göçükte ölür; fıtrat derler Kadın dayaktan ölür; kaşındı derler Zıt görüşlü biri ölür; hain derler Çocuk ihmalden ölür; kader derler. Demeye devam edecekler..